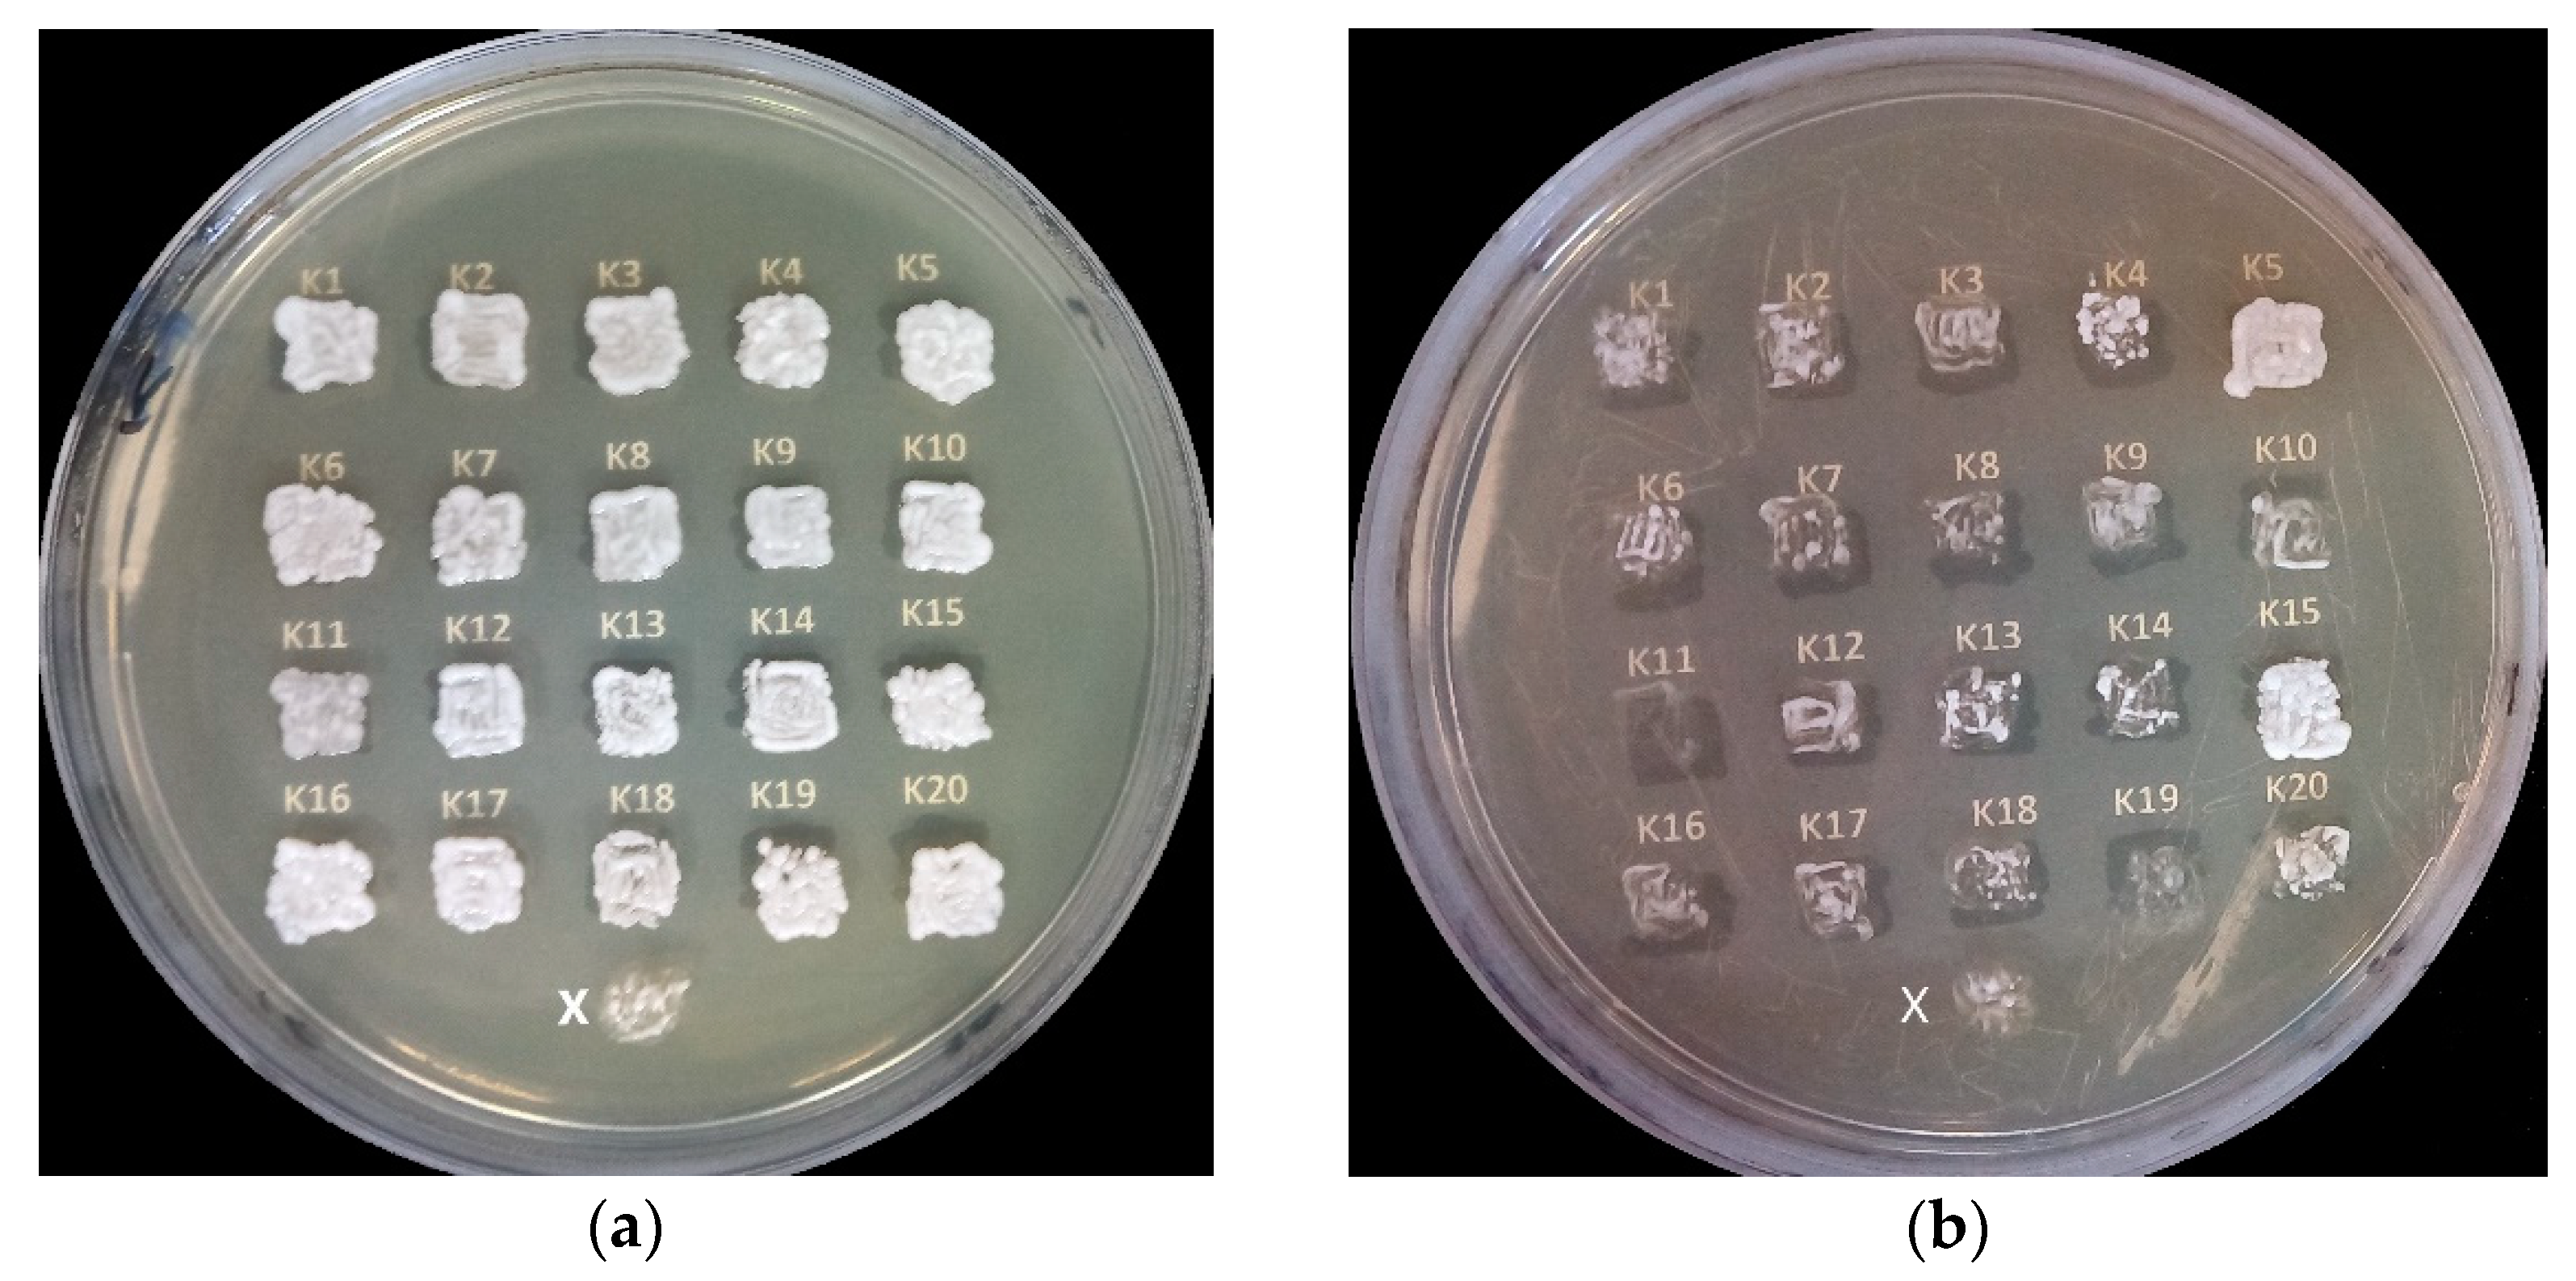
Fermentation 08 00283 g006
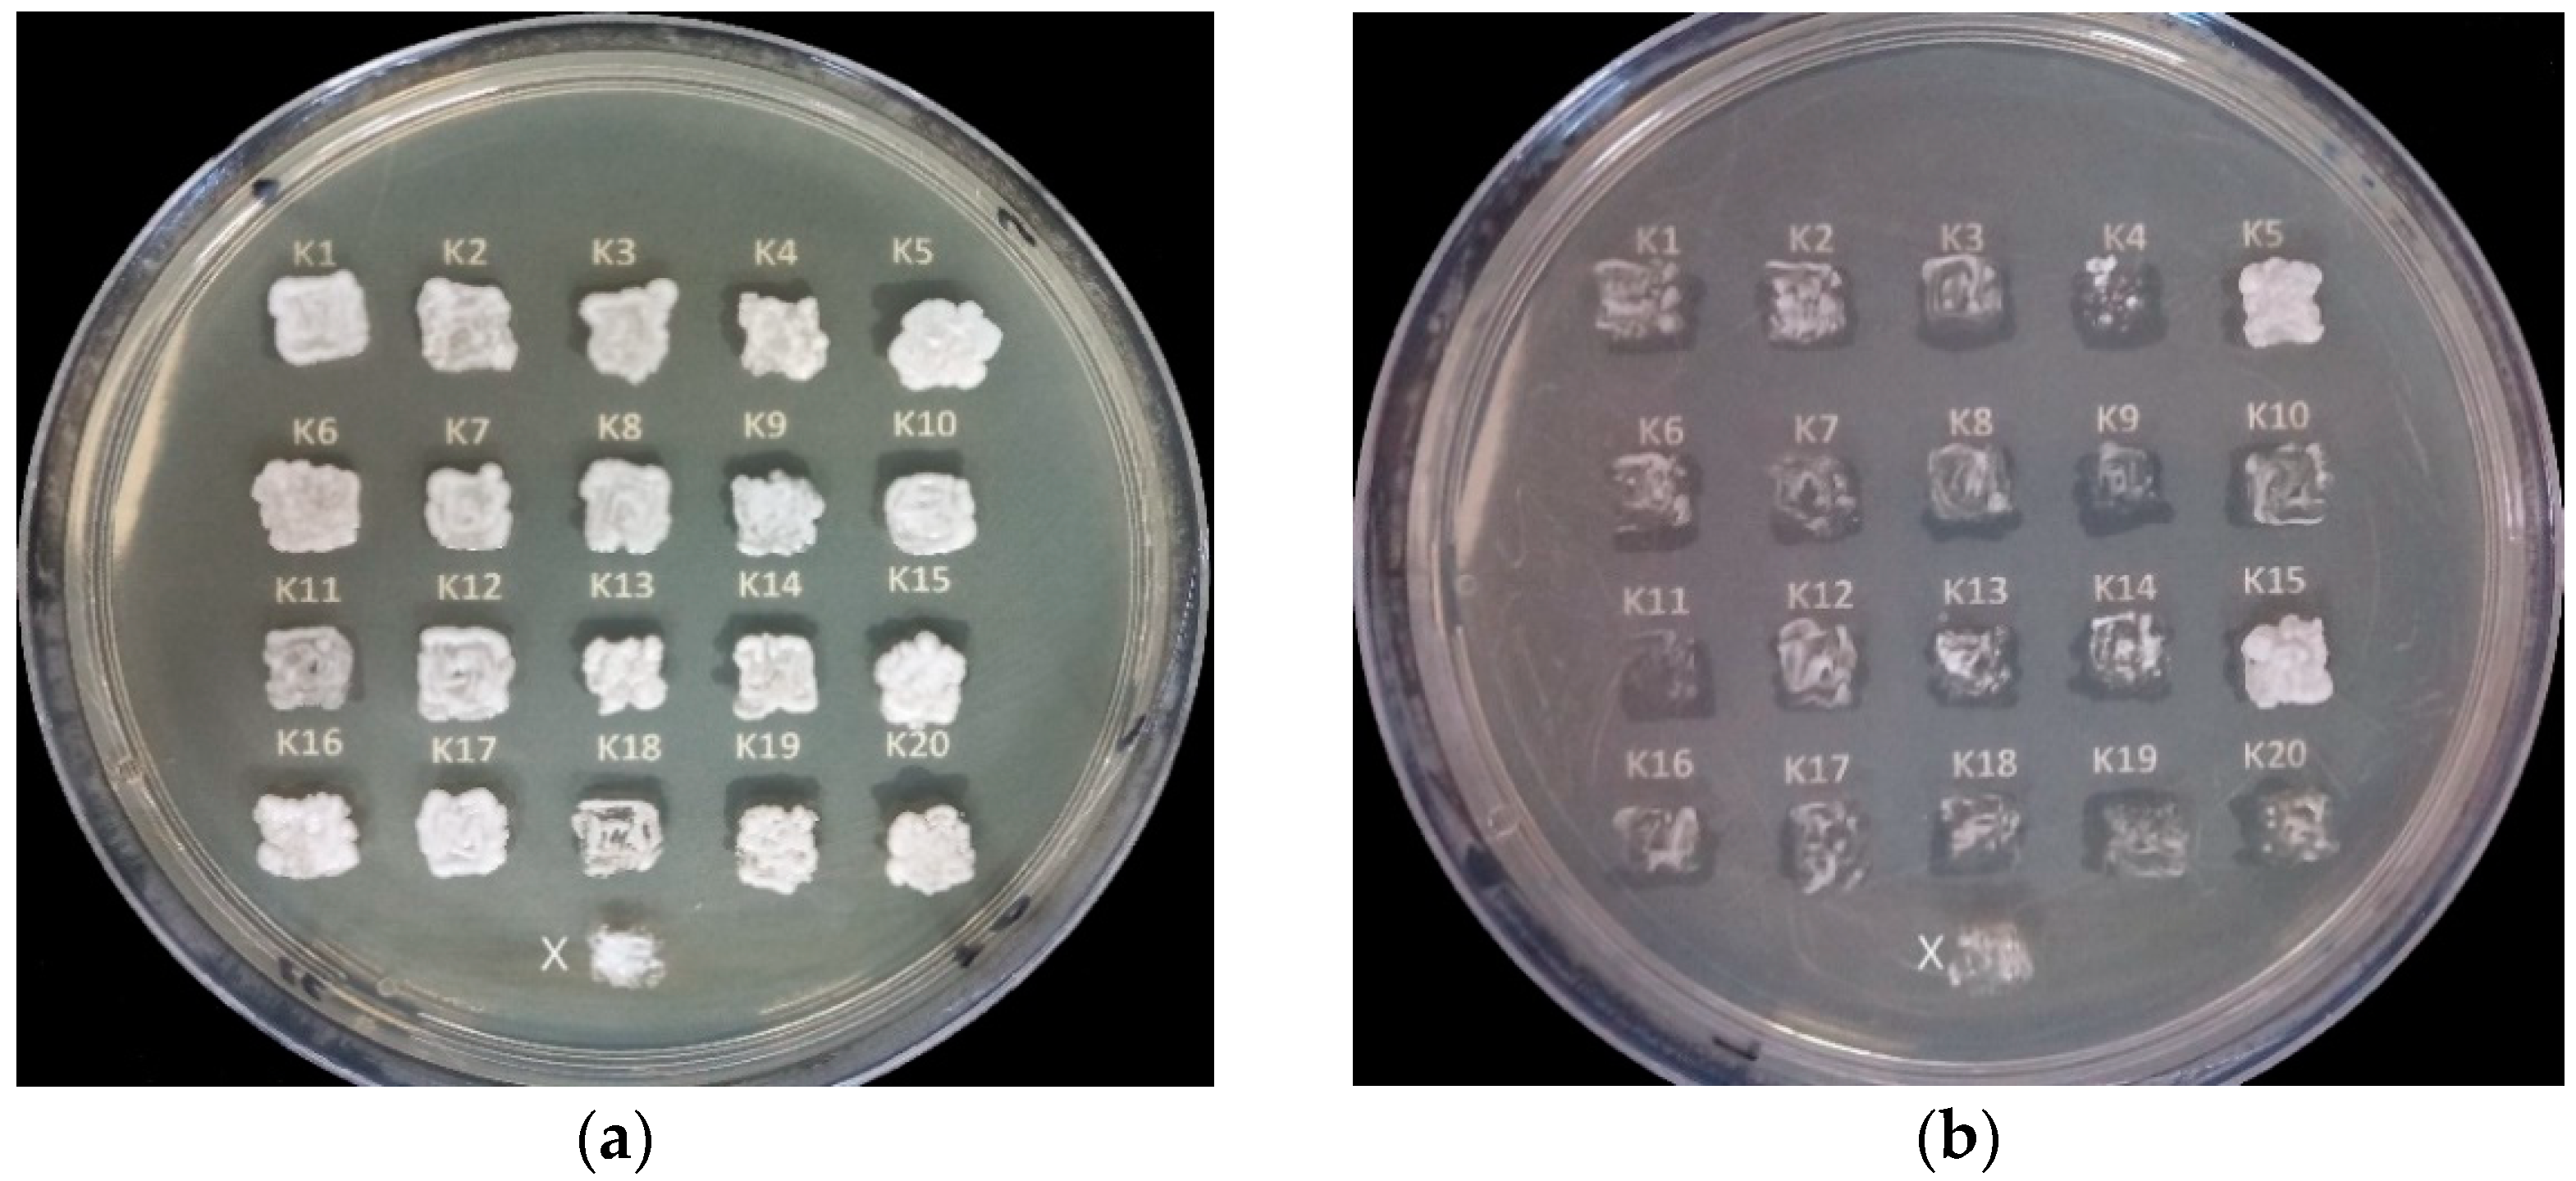
Fermentation 08 00283 g007
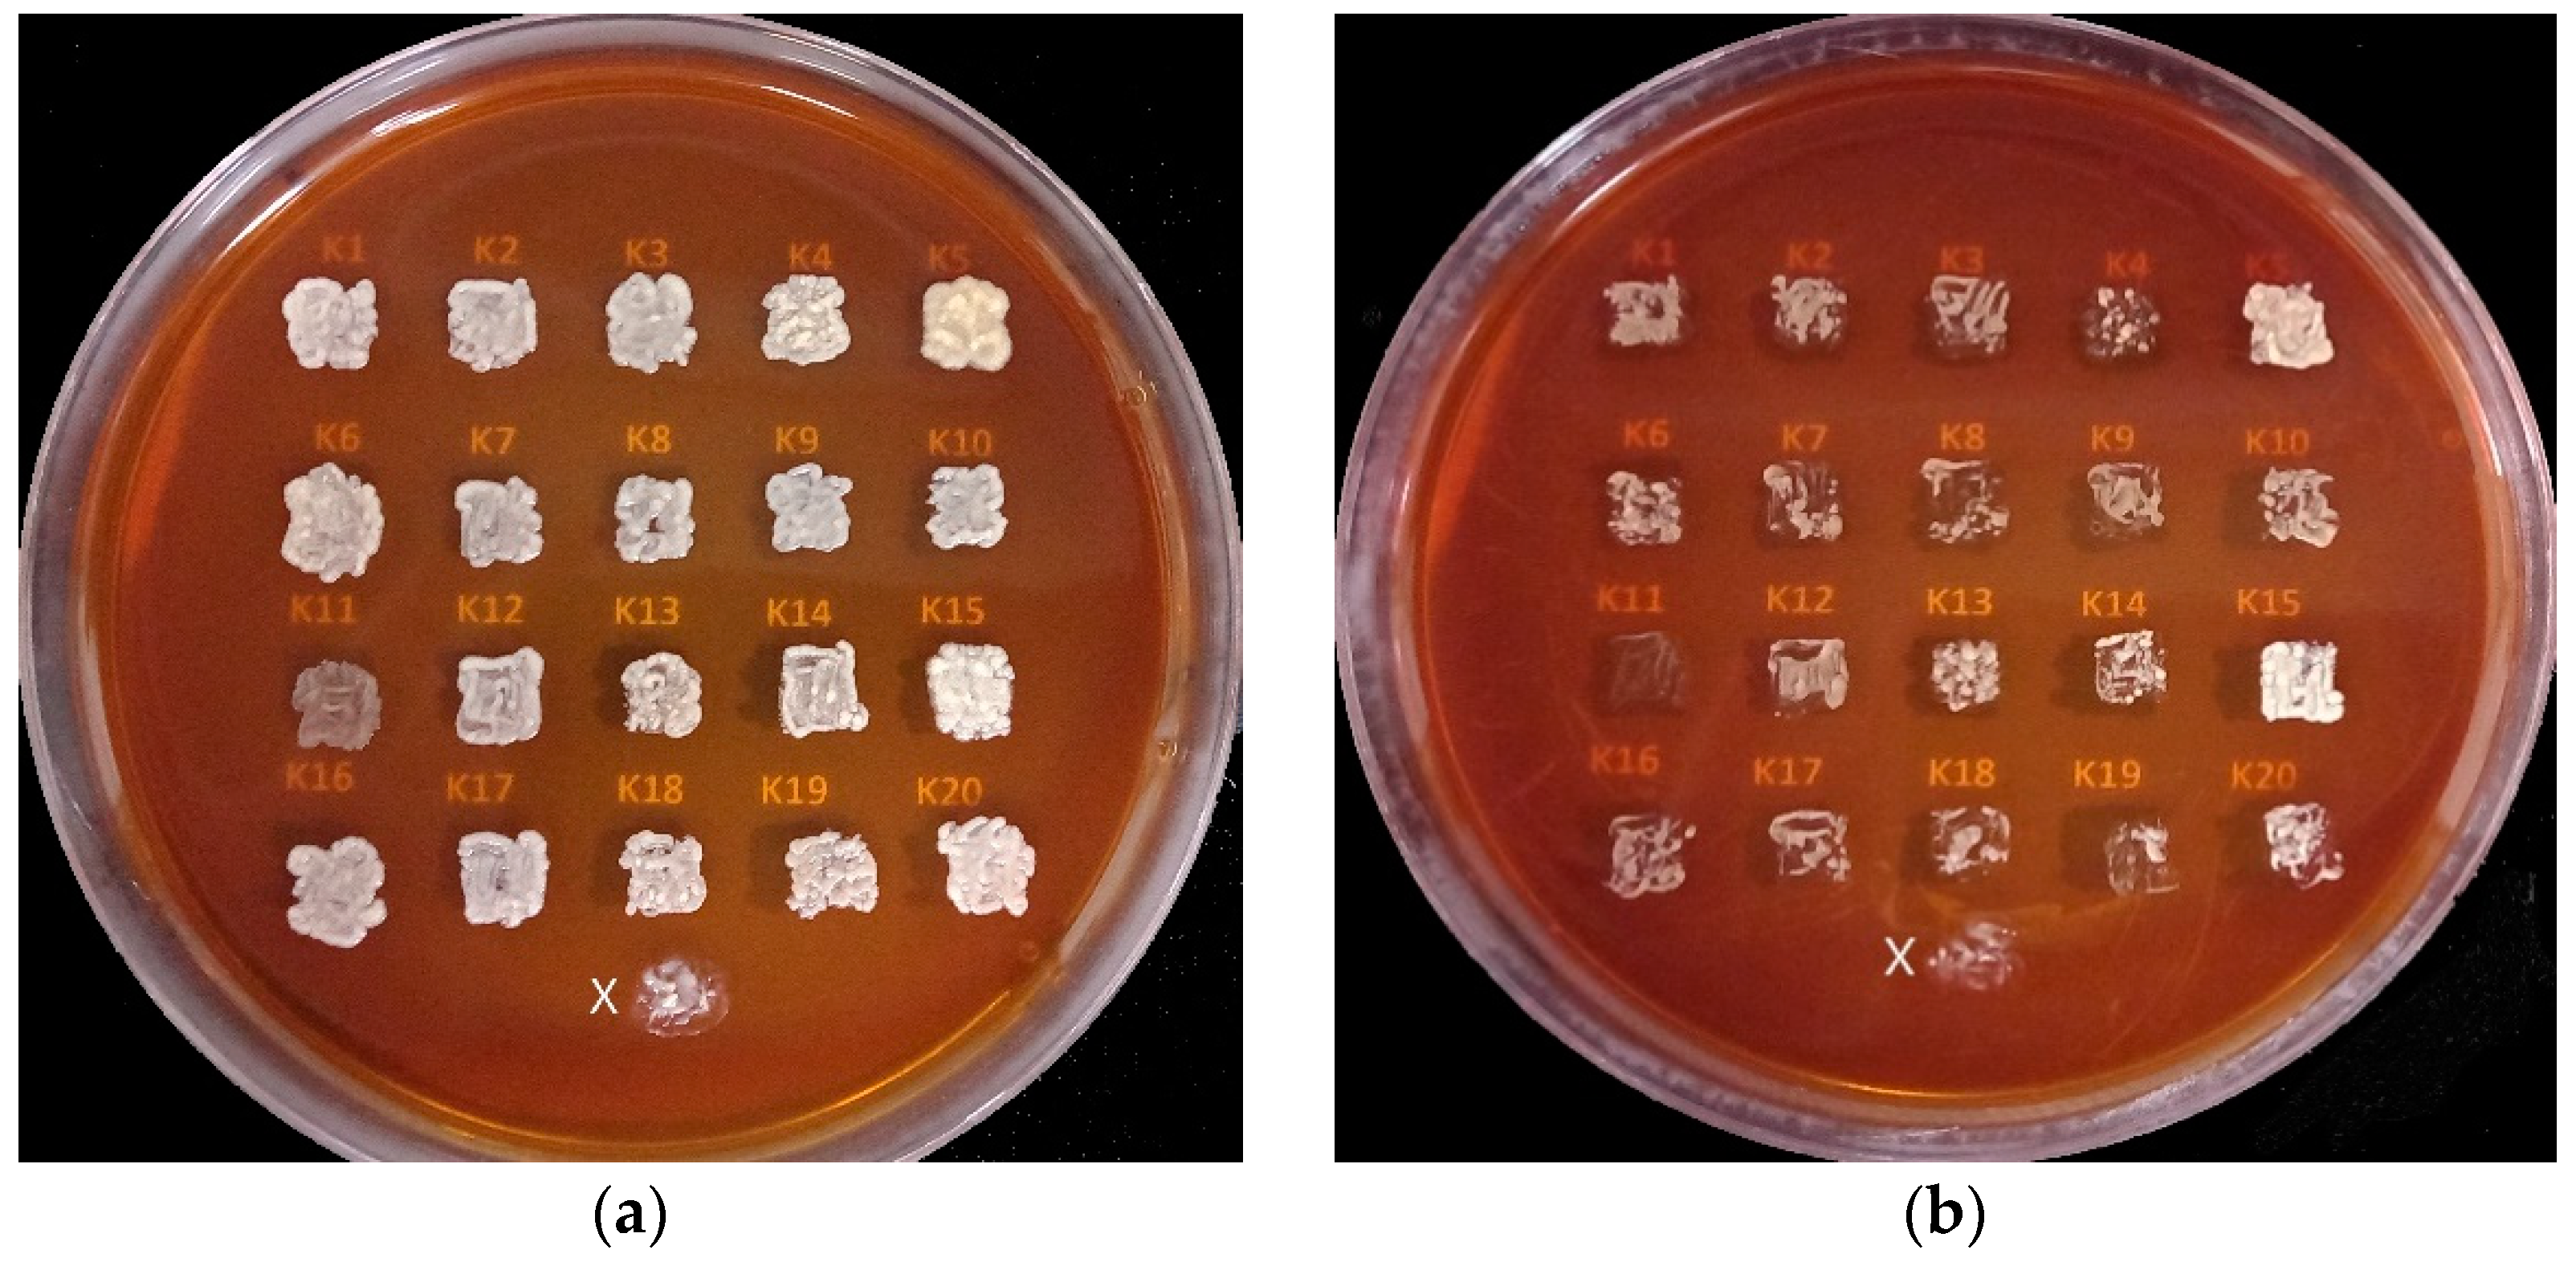
Fermentation 08 00283 g008

Isolation of Novel Yeast from Coconut (Cocos nucifera L.) Water and Phenotypic Examination as the Potential Parameters in Bioethanol Production
Abstract
1. Introduction
2. Materials and Methods
2.1. Sample Preparation
2.2. Yeast Isolation from Coconut Water (Cocos Nucifera L.)
2.3. Extraction of Yeast DNA Genome
2.4. DNA Sequencing
2.5. Phenotypic Test
3. Results
4. Discussion
5. Conclusions
Author Contributions
Funding
Institutional Review Board Statement
Informed Consent Statement
Data Availability Statement
Acknowledgments
Conflicts of Interest
References
- Rezania, R.; Oryani, B.; Cho, J.; Talaiekhozani, A.; Sabbagh, F.; Hashemi, B.; Rupani, F.P.; Mohammadi, A.A. Different pretreatment technologies of lignocellulosic biomass for bioethanol production: An overview. Energy 2020, 199, 117457. [Google Scholar] [CrossRef]
- Zentou, H.; Abidin, Z.Z.; Zouwanti, M.; Greetham, D. Effect of operating conditions on molasses fermentation for bioethanol production. Int. J. Appl. Eng. Res. 2017, 12, 5202–5506. [Google Scholar]
- Carillo-Nieves, D.; Alanis, J.R.M.; Quiroz, C.R.; Ruiz, A.H.; Iqbal, M.N.H.; Parra-Saldivar, R. Current status and future trends of bioethanol production from agroindustrial wastes in Mexico. Renew. Sustain. Energy Rev. 2019, 102, 63–74. [Google Scholar] [CrossRef]
- Vilela, A. The Importance of yeasts on fermentation quality and human health-promoting compounds. Fermentation 2019, 5, 46. [Google Scholar] [CrossRef]
- Balia, L.R.; Kurniani, A.B.; Utama, L.G. The Combination of Mozzarella Cheese Whey and Sugarcane Molasses in the Production of Bioethanol with the Inoculation of Indigenous Yeasts. J. Jpn. Inst. Energy 2018, 97, 266–269. [Google Scholar] [CrossRef]
- Kailaku, I.S.; Setiawan, B.; Sulaeman, A. The effects of ultrafiltration and ultraviolet process on nutritional composition, physicochemical and organoleptic properties of coconut water drink. J. Littri 2016, 22, 43–51. [Google Scholar] [CrossRef]
- Saraswati, D. Pengaruh Konsentrasi Air Kelapa Muda Terhadap Pertumbuhan Saccharomyces cereviceae. Master’s Thesis, Universitas negeri Gorontalo, Gorontalo, Indonesia, 2014. [Google Scholar]
- Bagaskara, A.; Wuijaya, M.M.I.; Antara, S.N. Isolation and characterization of bioethanol-producing bacteria from the arak industry of environment in the Tri Eka Buana village, Sidemen district, Karangasem Bali. J. Rekayasa Dan Manaj. Agroind. 2020, 8, 290–300. [Google Scholar] [CrossRef]
- Anita, W.N.; Admadi, H.B.; Arnata, W.I. Optimasi Konsentrasi Enzim Amiloglukosidase dan Saccharomyces cerevisiae dalam Pembuatan Bioetanol dari ubi jalar (Ipomoea batatas L.) varietas daya dengan proses sakarifikasi fermentasi simultan (SFS). J. Rekayasa Dan Manaj. Agroind. 2015, 3, 30–39. [Google Scholar]
- Maciel, N.O.P.; Piló, B.F.; Freitas, F.D.L.; Gomes, C.O.F.; Johann, S.; Nardi, M.D.R.; Lachance, M.; Rosa, A.C. The diversity and antifungal susceptibility of the yeasts isolated from coconut water and reconstituted fruit juices in Brazil. Int. J. Food Microbiol. 2013, 160, 201–205. [Google Scholar] [CrossRef]
- Arachchige, A.M.; Yoshida, S.; Toyama, H. Thermo-and salt-tolerant Saccharomyces cerevisiae strains isolated from fermenting coconut toddy from Sri Lanka. Biotechnol. Biotechnol. Equip. 2019, 33, 937–944. [Google Scholar] [CrossRef]
- Talukdera, A.A.; Easmina, F.; Mahmudb, A.S.; Yamada, M. Thermotolerant yeasts capable of producing bioethanol: Isolation from natural fermented sources, identification and characterization. Biotechnol. Biotechnol. Equip. 2016, 30, 1106–1114. [Google Scholar] [CrossRef]
- Demiray, E.; Karatay, E.S.; Dönmez, G. Efficient bioethanol production from pomegranate peels by newly isolated Kluyveromyces marxianus. Energy Sources Part A Recovery Util. Environ. Eff. 2019, 42, 709–718. [Google Scholar] [CrossRef]
- Kenga, S.E.; Easaa, M.A.; Muhamedb, M.A.; Ooib, C.; Chewa, T.T. Composition and physicochemical properties of fresh and freeze-concentrated coconut (Cocos nucifera) water. J. Agrobiotechnol. 2017, 8, 13–24. [Google Scholar]
- Alves, V.; Scapini, T.; Camargo, F.A.; Bonatto, C.; Stefanski, S.F.; Jesus, P.E.; Diniz, T.G.L.; Bertan, C.L.; Maldonado, R.R.; Treichel, H. Development of fermented beverage with water kefir in water-soluble coconut extract (Cocos nucifera L.) with inulin addition. LWT-Food Sci. Technol. 2021, 145, 111364. [Google Scholar] [CrossRef]
- Nouri, H.; Azin, M.; Mousafi, L.M. Xylan-hydrolyzing thermotolerant Candida tropicalis HNMA-1 for bioethanol production from sugarcane bagasse hydrolysate. Ann. Microbiol. 2017, 67, 633–641. [Google Scholar] [CrossRef]
- Balat, M.; Balat, H.; Oz, C. Progress in bioethanol processing. Prog. Energyand Combust. Sci. 2008, 34, 551–571. [Google Scholar] [CrossRef]
- Oliveira, A.C.; Fuess, T.L.; Soares, A.L.; Damianovic, Z.R.H.M. Thermophilic biohydrogen production from sugarcane molasses under low pH: Metabolic and microbial aspects. Int. Hydrog. Energy 2020, 45, 4182–4192. [Google Scholar] [CrossRef]
- Anggraini, A.S.; Yuniningsih, S.; Sota, M.M. Pengaruh pH terjadap kualitas produk etanol dari molase melalui proses fermentasi. J. Reka Buana 2017, 2, 99–105. [Google Scholar]
- Raharja, R.; Murdiyatmo, U.; Sutrisno, A.; Wardani, A.K. Bioethanol production from sugarcane molasses by instant dry yeast. IOP Conf. Ser. Earth Environ. Sci. 2019, 230, 012076. [Google Scholar] [CrossRef]
- Arshad, M.; Hussain, T.; Iqbal, M.; Abbas, M. Enhanced ethanol production at commercial scale from molasses using high gravity technology by mutant S. cerevisiae. Braz. J. Microbiol. 2017, 48, 403–409. [Google Scholar] [CrossRef]
- Kusmiyati, K.; Shitophyta, L.M. Produksi Bioetanol dari Bahan Baku Singkong, Jagung dan Iles-iles: Pengaruh Suhu Fermentasi dan Berat Yeast Saccharomyces cerevisiae. Reaktor 2014, 15, 97–103. [Google Scholar] [CrossRef][Green Version]
- Shariq, M.; Sohail, M. Application of Candida tropicalis MK-160 for the production of xylanase and ethanol. J. King Saud Univ. -Sci. 2019, 31, 1189–1194. [Google Scholar] [CrossRef]
- Hermansyah, H.; Novia, N.; Minetaka, S.; Satoshi, H. Candida tropicalis isolated from tuak, a North Sumatera-Indonesian traditional beverage, for bioethanol production. Microbiol. Biotechnol. Lett. 2015, 43, 241–248. [Google Scholar] [CrossRef]
- Wang, S.; Cheng, G.; Joshua, C.; He, Z.; Sun, X.; Li, R.; Liu, L.; Yuan, Q. Furfural tolerance and detoxification mechanism in Candida tropicalis. Biotechnol. Biofuels 2016, 9, 250. [Google Scholar] [CrossRef] [PubMed]
- Azoulay, E.; Jouanneau, F.; Bertrand, J.; Raphael, A.; Janssens, J.; Lebeault, M. Fermentation methods for protein enrichment of cassava and corn with Candida Tropicalis. Appl. Environ. Microbiol. 1980, 39, 41–47. [Google Scholar] [CrossRef] [PubMed]

| Isolate | Concentration (ng/µL) | A260/280 | A260/230 |
|---|---|---|---|
| K1 | 8.20 | 2.09 | 0.77 |
| K2 | 18.60 | 2.08 | 1.20 |
| K3 | 45.10 | 2.28 | 2.01 |
| K4 | 8.00 | 2.01 | 0.81 |
| K5 | 10.30 | 2.16 | 1.01 |
| K6 | 3.80 | 1.63 | 0.48 |
| K7 | 36.50 | 2.25 | 1.52 |
| K8 | 79.90 | 1.84 | 0.60 |
| K9 | 33.50 | 1.94 | 0.60 |
| K10 | 59.80 | 2.34 | 2.03 |
| K11 | 43.40 | 1.85 | 0.49 |
| K12 | 7.00 | 2.28 | 0.97 |
| K13 | 17.70 | 2.12 | 1.11 |
| K14 | 4.80 | 1.94 | 0.62 |
| K15 | 11.10 | 1.86 | 0.73 |
| K16 | 4.30 | 5.35 | 0.48 |
| K17 | 5.00 | 1.64 | 0.52 |
| K18 | 5.10 | 1.77 | 0.57 |
| K19 | 7.10 | 2.98 | 0.92 |
| K20 | 7.00 | 1.64 | 0.48 |
| Isolate | Accession Number | Species | Max Score | Total Score | Query Coverage | E Value | Percent Identity |
|---|---|---|---|---|---|---|---|
| K1 | KT226114.1 | Henseniaspora opuntiae strain NS02 | 1351 | 1351 | 99% | 0.0 | 99.86% |
| K2 | KY103531.1 | Henseniaspora meyeri culture CBS:8775 | 959 | 959 | 100% | 0.0 | 99.81% |
| K3 | KY103531.1 | Henseniaspora meyeri culture CBS:8775 | 952 | 952 | 100% | 0.0 | 99.81% |
| K4 | MK394110.1 | Meyerozima carpophila strain CBS5256 | 1083 | 1083 | 99% | 0.0 | 99.83% |
| K5 | MK752673.1 | Candida tropicalis strain L2 | 898 | 898 | 100% | 0.0 | 99.81% |
| K6 | KY497945.1 | Henseniaspora opuntiae strain F173 | 935 | 935 | 100% | 0.0 | 100% |
| K7 | KY103531.1 | Henseniaspora meyeri culture CBS:8775 | 957 | 957 | 100% | 0.0 | 100% |
| K8 | KY103531.1 | Henseniaspora meyeri culture CBS:8775 | 953 | 953 | 99% | 0.0 | 100% |
| K9 | CP024006.1 | Saccharomyces cerevisiae strain KSD-Yc | 1520 | 1520 | 99% | 0.0 | 100% |
| K10 | KY103531.1 | Henseniaspora meyeri culture CBS:8775 | 957 | 957 | 100% | 0.0 | 100% |
| K11 | AB501145.1 | Henseniaspora thailandica | 1347 | 1347 | 97% | 0.0 | 100% |
| K12 | KM402049.1 | Meyerozima carribica Strain UFLA CWFY11 | 1105 | 2215 | 100% | 0.0 | 99.51% |
| K13 | KY103531.1 | Henseniaspora meyeri culture CBS:8775 | 952 | 952 | 99% | 0.0 | 99.81% |
| K14 | CP024006.1 | Saccharomyces cerevisiae strain KSD-Yc | 1515 | 10,502 | 100% | 0.0 | 100% |
| K15 | CP047875.1 | Candida tropicalis strain MYA-3404 | 948 | 2845 | 99% | 0.0 | 99.61% |
| K16 | KP132361.1 | Lanchance fermentati strain CNRMA8.216 | 1221 | 1221 | 99% | 0.0 | 99.70% |
| K17 | MK394110.1 | Meyerozima carribica strain CBS 5256 | 1123 | 1123 | 99% | 0.0 | 100% |
| K18 | FM178396.1 | Candida othopsilosis | 948 | 948 | 99% | 0.0 | 100% |
| K19 | KY103573.1 | Henseniaspora ovarum culture CBS:2580 | 1312 | 1312 | 99% | 0.0 | 99.91% |
| K20 | KT459476.1 | Candida tropicalis strain Y277 | 974 | 974 | 100% | 0.0 | 100% |
| Isolate | Growth | |||||
|---|---|---|---|---|---|---|
| 30 °C | 41 °C | |||||
| YPDA Media | YPDA pH 3.5 Media | YPA-Molase 35°brix Media | YPDA Media | YPDA pH 3.5 Media | YPA-Molase 35 °brix Media | |
| K1 | +++ | +++ | +++ | ++ | ++ | ++ |
| K2 | +++ | +++ | +++ | ++ | ++ | ++ |
| K3 | +++ | +++ | +++ | ++ | ++ | ++ |
| K4 | +++ | +++ | +++ | +++ | ++ | ++ |
| K5 | +++ | +++ | +++ | +++ | +++ | +++ |
| K6 | +++ | +++ | +++ | ++ | ++ | ++ |
| K7 | +++ | +++ | +++ | ++ | ++ | ++ |
| K8 | +++ | +++ | +++ | ++ | ++ | ++ |
| K8 | +++ | +++ | +++ | ++ | ++ | ++ |
| K9 | +++ | +++ | +++ | ++ | + | ++ |
| K10 | +++ | +++ | +++ | ++ | ++ | ++ |
| K11 | +++ | +++ | + | + | + | + |
| K12 | +++ | +++ | +++ | ++ | ++ | ++ |
| K13 | +++ | +++ | +++ | ++ | ++ | ++ |
| K14 | +++ | +++ | +++ | ++ | ++ | ++ |
| K15 | +++ | +++ | +++ | ++ | +++ | +++ |
| K16 | +++ | +++ | +++ | ++ | ++ | ++ |
| K17 | +++ | +++ | +++ | ++ | ++ | ++ |
| K18 | +++ | +++ | +++ | ++ | ++ | ++ |
| K19 | +++ | +++ | +++ | + | ++ | + |
| K20 | +++ | +++ | +++ | +++ | ++ | +++ |
| X | ++ | +++ | +++ | + | + | + |
Publisher’s Note: MDPI stays neutral with regard to jurisdictional claims in published maps and institutional affiliations. |
© 2022 by the authors. Licensee MDPI, Basel, Switzerland. This article is an open access article distributed under the terms and conditions of the Creative Commons Attribution (CC BY) license (https://creativecommons.org/licenses/by/4.0/).
Share and Cite
Kasmiarti, G.; Oktiarni, D.; Hariani, P.L.; Novia, N.; Hermansyah, H. Isolation of Novel Yeast from Coconut (Cocos nucifera L.) Water and Phenotypic Examination as the Potential Parameters in Bioethanol Production. Fermentation 2022, 8, 283. https://doi.org/10.3390/fermentation8060283
Kasmiarti G, Oktiarni D, Hariani PL, Novia N, Hermansyah H. Isolation of Novel Yeast from Coconut (Cocos nucifera L.) Water and Phenotypic Examination as the Potential Parameters in Bioethanol Production. Fermentation. 2022; 8(6):283. https://doi.org/10.3390/fermentation8060283
Chicago/Turabian StyleKasmiarti, Getari, Dwita Oktiarni, Poedji Loekitowati Hariani, Novia Novia, and Hermansyah Hermansyah. 2022. "Isolation of Novel Yeast from Coconut (Cocos nucifera L.) Water and Phenotypic Examination as the Potential Parameters in Bioethanol Production" Fermentation 8, no. 6: 283. https://doi.org/10.3390/fermentation8060283
APA StyleKasmiarti, G., Oktiarni, D., Hariani, P. L., Novia, N., & Hermansyah, H. (2022). Isolation of Novel Yeast from Coconut (Cocos nucifera L.) Water and Phenotypic Examination as the Potential Parameters in Bioethanol Production. Fermentation, 8(6), 283. https://doi.org/10.3390/fermentation8060283

